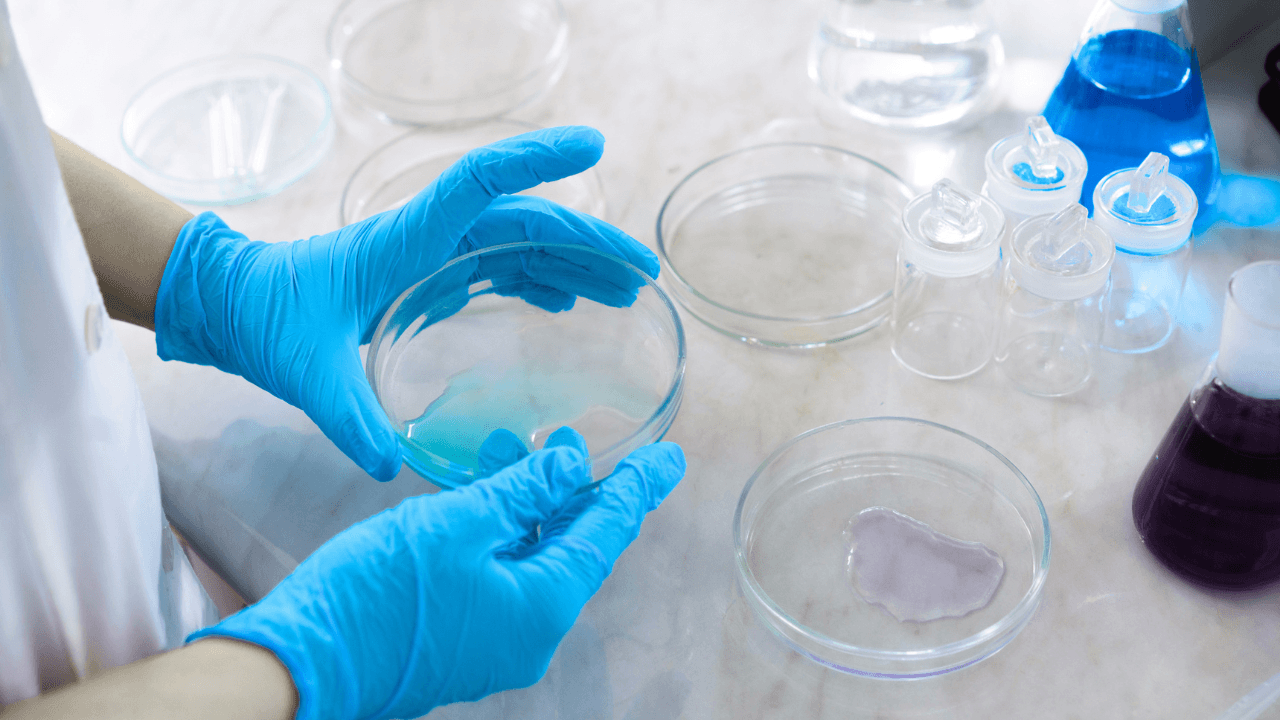
Nitrile-the-Strongest-and-Most-Reliable-Glove-Material

Nitrile has dominated the disposable glove market for good reason. It resists punctures, handles chemicals, and suits workers with latex sensitivities. For bulk buyers, it became the default choice almost by inertia. But default does not mean flawless. Procurement managers running high-volume operations are finding gaps between what nitrile promises and what it delivers.
The question is worth asking directly: Is nitrile actually the strongest and most reliable option available? The honest answer is more complicated than the marketing suggests.
The Case for Nitrile, and Its Limits
Nitrile outperforms latex in chemical resistance and vinyl in tensile strength. For most industrial, food handling, and healthcare applications, it remains a sound material choice. That much is accurate.
What is less discussed is performance variance. Not all nitrile is equal. Budget-grade gloves, typically 3 to 5 mil in thickness, are where the problems concentrate. Machinists, laboratory technicians, and food processing workers report failure rates that go well beyond acceptable. Gloves are splitting on application. Batches where 20 to 25 percent arrive already torn. Micro-failures during flexion that leave no visible hole but allow contamination to pass through.
In surgical and clinical settings, studies have recorded unnoticed breach rates above 50 percent in operative environments. In cleanroom testing, nitrile gloves have failed water-leak assessments at rates approaching 50 percent in some analyses. These are not anecdotal complaints. They represent a structural problem in how budget nitrile performs under real conditions.
Thicker gloves, 6 to 9 mil, perform better on durability metrics. The trade-off is reduced dexterity, which slows output in precision tasks. Buyers end up choosing between performance risk and productivity loss.
Chemical Exposure and the Degradation Problem
Nitrile’s chemical resistance has limits that industrial buyers learn quickly. Coolants, solvents, alcohols, and oil-based compounds break down nitrile faster than expected. Workers in automotive, food manufacturing, and engineering environments report going through entire boxes in a single week.
This is a cost and waste issue simultaneously. Gloves failing mid-task create contamination risk. They also drive consumption volume beyond what purchasing projections account for. What looked like an affordable per-unit cost can erode quickly when replacement rates are factored in.
For businesses managing procurement at scale, failure frequency is not a minor inconvenience. A glove piece entering a food production line is a recall waiting to happen. Chemical exposure through a degraded barrier is a worker safety incident.
The Environmental Weight of Standard Nitrile
Nitrile is petroleum-derived. A standard nitrile glove discarded in a landfill can persist for centuries. At industrial volumes, this translates directly into growing disposal costs, increasing regulatory exposure, and mounting ESG reporting pressure.
Sustainability requirements are no longer soft preferences in large procurement decisions. Corporate supply chain standards, client expectations, and emerging single-use plastics legislation are pushing operations managers to look harder at what ends up in their waste stream. Nitrile, used at scale, is a significant contributor.
Biohazard streams in healthcare settings typically incinerate glove waste regardless. But food production, light manufacturing, and logistics operations do not operate under those constraints. Their nitrile waste goes to a landfill, and it stays there.
Where Biodegradable Nitrile Changes the Calculation
The argument for biodegradable nitrile is not primarily an ethical one, though that holds weight. It is a practical and commercial one.
Biodegradable nitrile, when manufactured to the same tensile and puncture resistance standards as premium conventional nitrile, gives operations managers something they have not had before: performance parity with a materially better disposal outcome. Earth Safe PPE’s biodegradable nitrile gloves break down up to 90 percent within 490 days under landfill conditions. Standard nitrile in the same environment does not meaningfully degrade at all.
That is not a marginal improvement. It is a fundamental shift in what happens after the glove is used.
Aged-sample testing has shown that biodegradable nitrile can actually record higher tensile strength than standard nitrile in some evaluations. The accelerated breakdown is activated by microbial conditions in the landfill, not by handling or storage. The glove behaves as expected during use and degrades appropriately post-disposal.
For procurement managers facing ESG targets, plastic reduction mandates, or client-facing sustainability commitments, this is the answer that does not require workflow change. The glove goes on the same way. It does the same job. It does not add to a centuries-long waste problem.
What Bulk Buyers Actually Need to Know
Businesses purchasing at $1M+ volumes are not buying on product descriptions. They need verified data. Tensile strength figures. Elongation at break. AQL ratings. Third-party certifications.
Earth Safe PPE was founded by Peter and Jakub, professionals with nearly two decades of combined experience across Environmental Health and Safety and construction sales. They built the company specifically because they had seen the waste, inconsistency, and hidden costs of conventional PPE from the inside. The product is FDA-compliant and ASTM D5511 certified, the standard for anaerobic biodegradation under landfill conditions.
Managing Director Eamonn O’Keeffe of S Tyres noted that the gloves met both operational requirements and environmental goals, comfortable, well-constructed, and practical across a factory floor. That is a real-use endorsement from an operations context, not a laboratory setting.
The Reliability Question, Answered Directly
Is nitrile the strongest disposable glove material overall? In premium grades, it competes with latex on most performance metrics and exceeds vinyl. As a category, it is reliable when quality control is enforced.
The problem is that quality control is not consistently enforced across the market. Budget imports flood purchasing channels. Spec sheets do not always reflect what arrives in the box. Operations that depend on high-volume glove use are exposed to the variance that comes with treating nitrile as a commodity.
Biodegradable nitrile, produced to verifiable standards, removes two problems at once: it addresses the quality inconsistency buyers experience with substandard conventional gloves, and it solves the disposal burden that procurement teams are increasingly held accountable for.
That combination is why the comparison is shifting. It is not biodegradable versus standard anymore. It is a reliable biodegradable versus an unreliable standard, and the former is increasingly winning the argument.
Upgrade your operation confidently! Our FDA-compliant biodegradable nitrile gloves deliver the protection and assurance you need to meet the highest food safety standards, all while providing a simple, positive step toward sustainability. Contact our sales team immediately for verified product certifications and bulk pricing: Call +44 7482 212945 or visit our contact page.